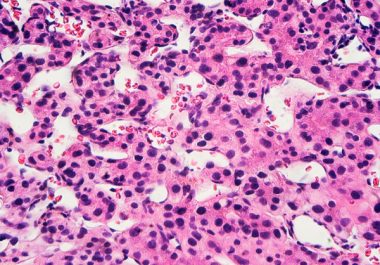

Post-surgery Option for Liver Cancer
New study finds drug combination after surgery helps prevent recurrence in liver cancer patients.


New study finds drug combination after surgery helps prevent recurrence in liver cancer patients.

Study results show stereotactic body radiation therapy could be added to standard care.

Metastatic cancer patients nearing death continue to receive high-dose radiation despite guidelines advising against it, and new standards are likely to reduce racial disparities in lung cancer screening.

The FDA has granted accelerated approval to a molecularly targeted therapeutic along with a companion diagnostic to treat certain patients with cholangiocarcinoma. The U.S. Food and Drug Administration (FDA) has granted accelerated approval to...
The FDA approved a combination of an immunotherapy and a therapeutic that can stop tumors from growing blood vessels for certain patients with liver cancer.

The FDA has approved an alternative dosing schedule for the immune checkpoint inhibitor pembrolizumab.

The first molecularly targeted therapeutic for use in the treatment of bile duct cancer has been approved by the FDA.

Experts offer information and cancer centers take precautions in light of the novel coronavirus, and the Food and Drug Administration approves an immunotherapy combination for liver cancer.

The FDA approved using a combination of nivolumab and ipilimumab, two immune checkpoint inhibitors, to treat certain patients with hepatocellular carcinoma.

The FDA expanded the use of the immunotherapy pembrolizumab to include the treatment of certain patients with liver cancer.